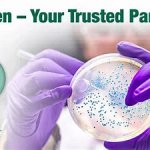

人類幹細胞激素/肥大細胞生長因子(SCF/MGF)試劑盒 | Human Stem cell factor/mast cell growth factor (SCF/MGF) ELISA Kit 貨號CK-bio-13522

人類膠質細胞系衍生神經營養因子 (GDNF) 試劑盒 | Human Glial Cell Line-Derived Neurotrophic Factor (GDNF) ELISA Kit 貨號CK-bio-11615

海藻糖含量測定試劑盒| Trehalose Content Assay Kit 貨號AK0294-100T-96S

EMB伊紅美藍瓊脂培養基 (Levine) | Eosin Methylene Blue Agar貨號NCM0105A

蛋白腖緩衝液 Buffered Peptone Water (BPW) | 貨號NCM0003A

沙氏葡萄糖瓊脂(Sabouraud Dextrose Agar) | 貨號NCM0008A

Terrific Broth, Modified | 貨號 NCM0278A

甘露醇 鹽瓊脂(Mannitol Salt Agar)| NEOGEN貨號NCM0078A

PCA總生菌數檢測 (Standard Methods) | Plate Count Agar貨號NCM0010A

Middlebrook 7H11培養基 | NEOGEN貨號NCM0043A